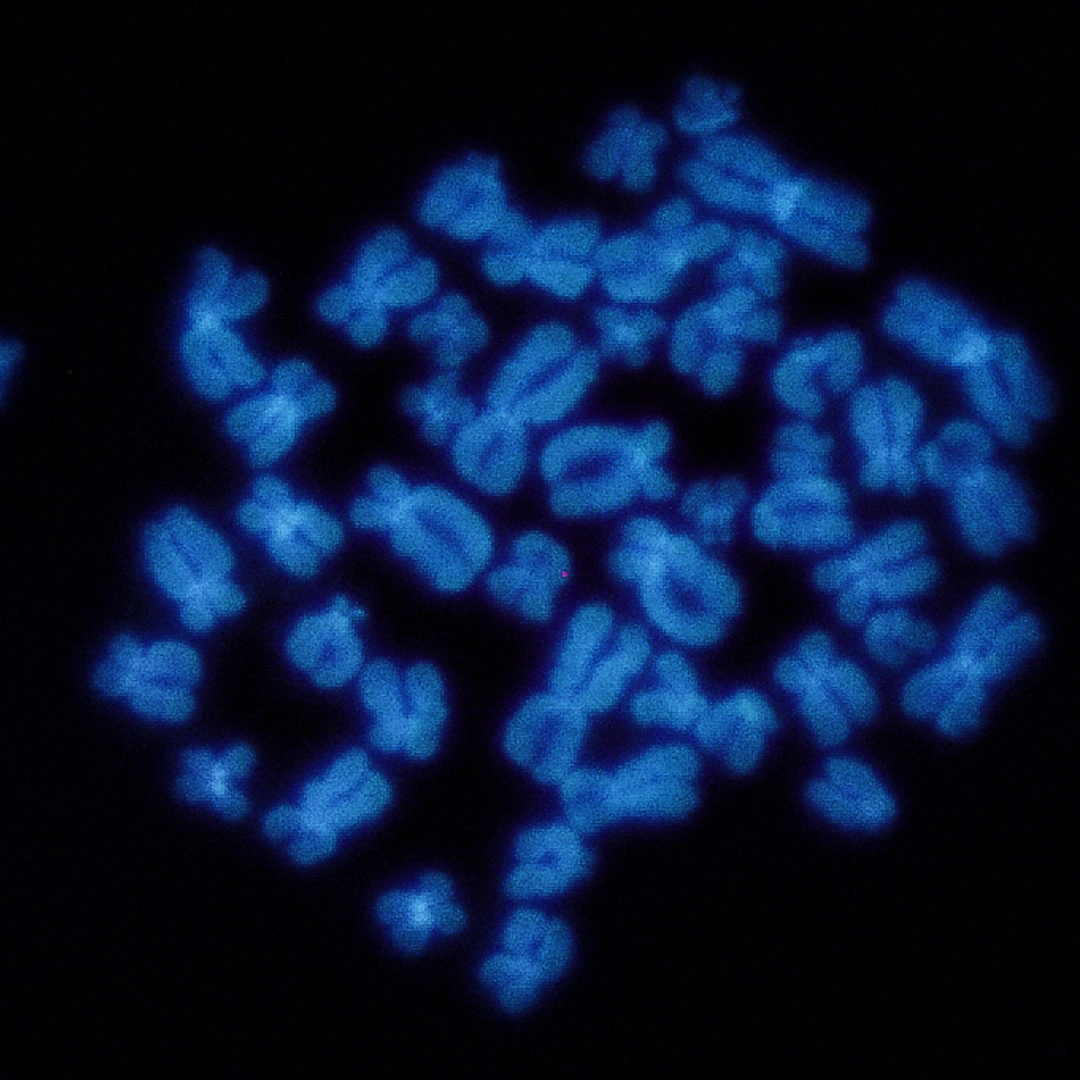
DELETION 17P, P53 (M MYE- LOMA, CLL) LEUKEMIC FISH

Help & Support
All Test
All Tests
- Blood Test
Popular Tests
- Plasma Test
Popular Tests
- Cancer Test
Popular Tests
- Liver Test
Popular Tests
-
- Kidney Test
Popular Tests
- Pregnancy Test
Popular Tests
- Thyroid Test
Popular Tests
- Blood Test
Popular Tests
- Plasma Test
Popular Tests
- Cancer Test
Popular Tests
- Liver Test
Popular Tests
-
- Kidney Test
Popular Tests
- Pregnancy Test
Popular Tests
- Thyroid Test
Popular Tests
Packages
Packages
0
No products in the cart.

Reviews
There are no reviews yet.